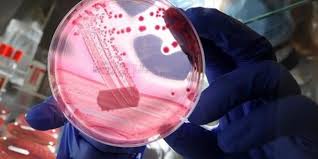

باحثون يطورون جرعة تحصينية للسيطرة على جرثومة الكوليرا
في خطوة جديدة على طريق القضاء على مرض الكوليرا، نجح باحثون أمريكيون في تطوير جرعة تحصينية واحدة من لقاح مكافح للجرثومة المسببة للكوليرا، ويسمى اللقاح "فاكسشورا" ويتم أخذه في جرعة فموية، وحصل على موافقة إدارة الأغذية والدواء الأمريكية للإستخدام بين البالغين في الفئة العمرية ما بين 18- 64 عامًا.
وقيم العلماء في جامعة واشنطن، فاعلية وقدرة المصل على تحفيز الأجسام المضادة للاستجابة المناعية المرتبطة بالحماية من المرض في ظل الجرعات العالية من جرعة تحصينية واحدة من لقاح الكوليرا الجديد المطور.
وأوضح العلماء أن الاعتماد على لقاح فموي في جرعة واحدة يعد الأقوى على طريق الأمصال المكافحة لجرثومة الكوليرا، التي باتت تتفشى في عديد من المجتمعات الفقيرة ذات الدخل المنخفض أو تنعدم بها نظم الرعاية الطيبة اللازمة.
أكد الدكتور مايرون ليفين، أستاذ المناعة بجامعة واشنطن - في بيان صحفي - إن "التحصين بواسطة جرعة واحدة من مصل الكوليرا يمكن أن يساعد في سرعة حماية الفئات الأكثر عرضة للإصابة بالكوليرا؛ خاصة في البلدان ذات الدخل المنخفض، ما سيصبح من الأسلحة الهامة على طريق مكافحة تفشي الأمراض وخفض معدل الوفيات"، وأضاف، "نظرا للنتائج المشجعة المتوصل إليها، فإننا نتصور أنه على سبيل الأولوية جرعة عالية من هذا المصل سيقي بشكل كامل البلدان ذات الدخل المنخفض، خاصة في مناطق إفريقيا، وآسيا ومنطقة البحر الكاريبي، من خطر الكوليرا الذي يهددها".

























